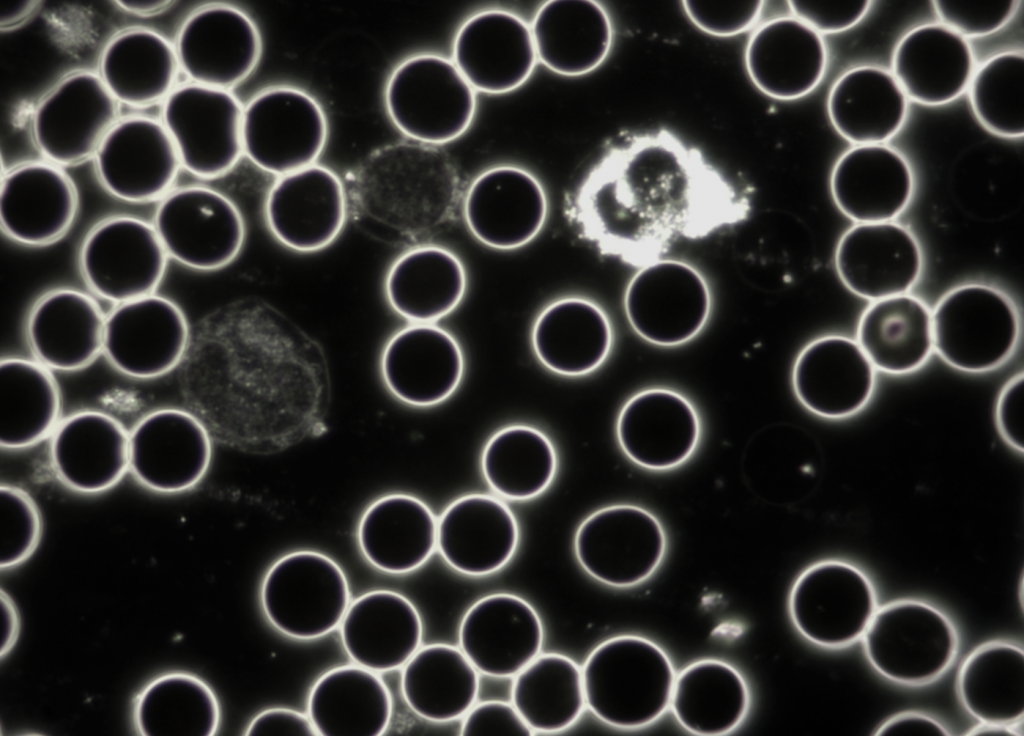
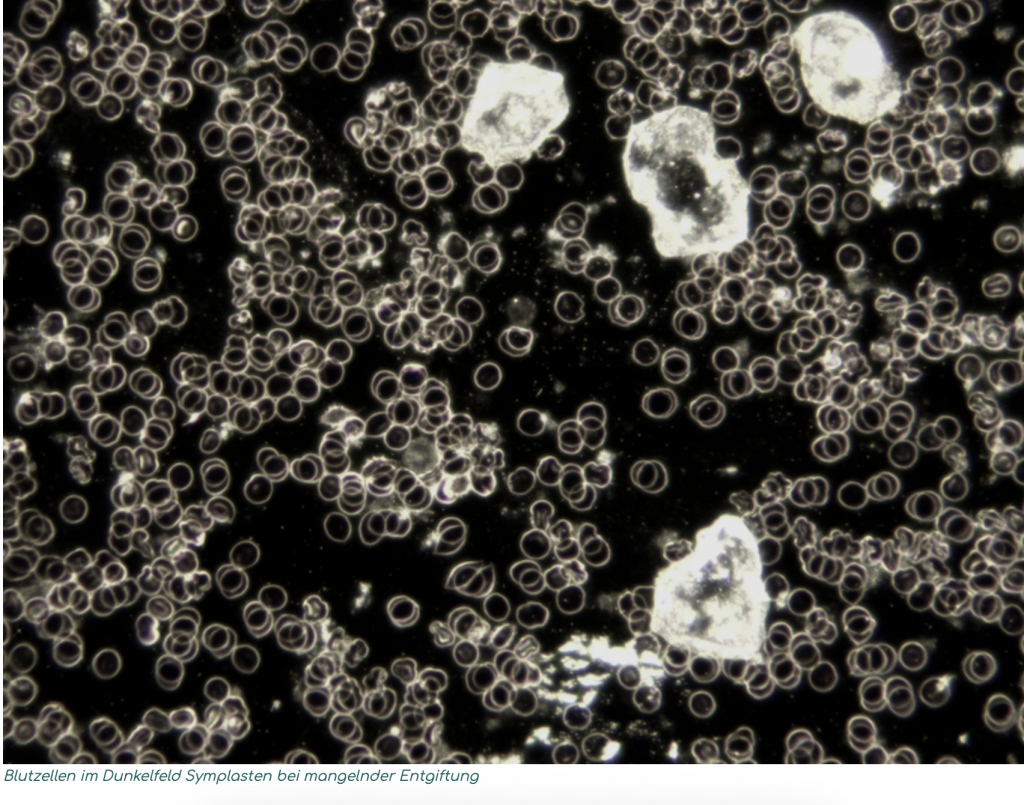
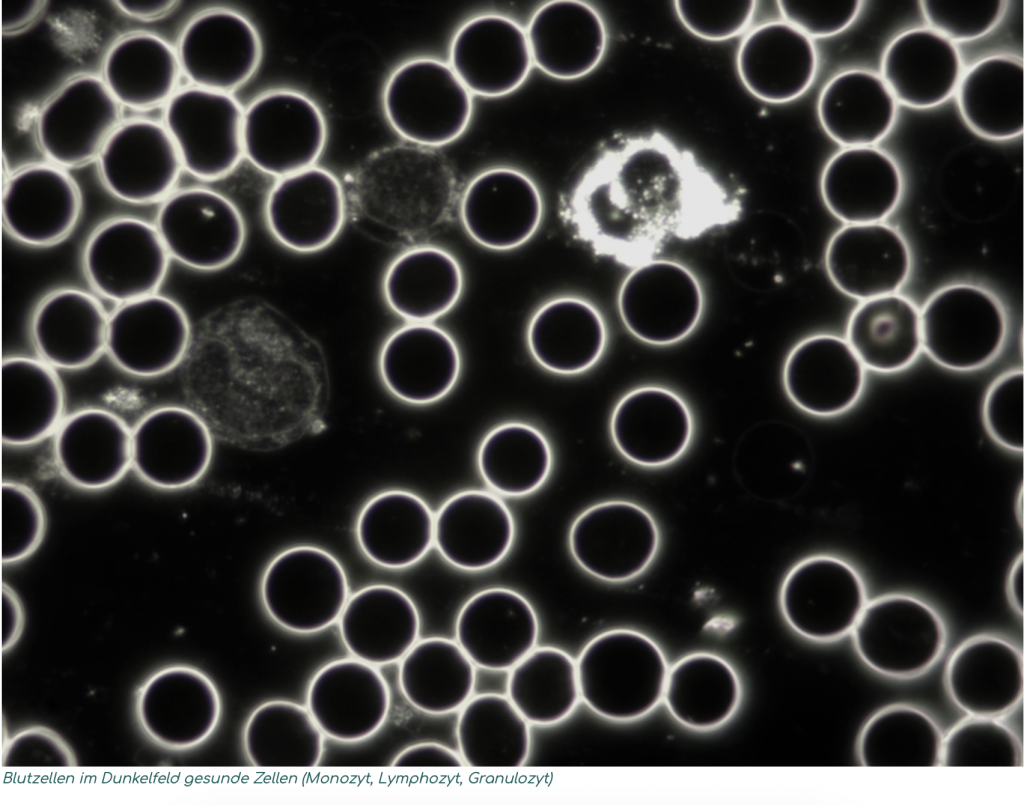

Wie wird die Dunkelfeld-Diagnostik durchgeführt?
Für die Dunkelfeldmikroskopie benötigt man nur einen kleinen Tropfen Blut aus der Fingerbeere oder dem Ohrläppchen, dazu sollte der Patient am besten nüchtern oder mindestens 2 Stunden nüchtern in die Praxis kommen. Die Hände sollten nicht eingecremt sein, da die Creme das Ergebnis bei der Blutentnahme verfälschen kann.
Der Tropfen wird im Beisein des Patienten auf einem Objektträger mikroskopiert und kann währenddessen auf dem Monitor beobachtet werden. Hier kann der Patient die Bewegung und Lebendigkeit seines eigenen Blutes sehen.
Die Dunkelfeld-Vitalblutdiagnostik erlaubt Aussagen über:
-
die Zusammensetzung der roten und weißen Blutkörperche
-
die Aktivität des Immunsystems
-
die Sauerstoffversorgung des Blutes
-
das Ausmaß der mikrobiellen und toxischen Belastung des Blutes
-
die Stoffwechselsituation und Entgiftungsfähigkeit des Körpers
-
der Grad der Übersäuerung
-
die Fließeigenschaften des Blutes und eventuell das Thromboserisiko